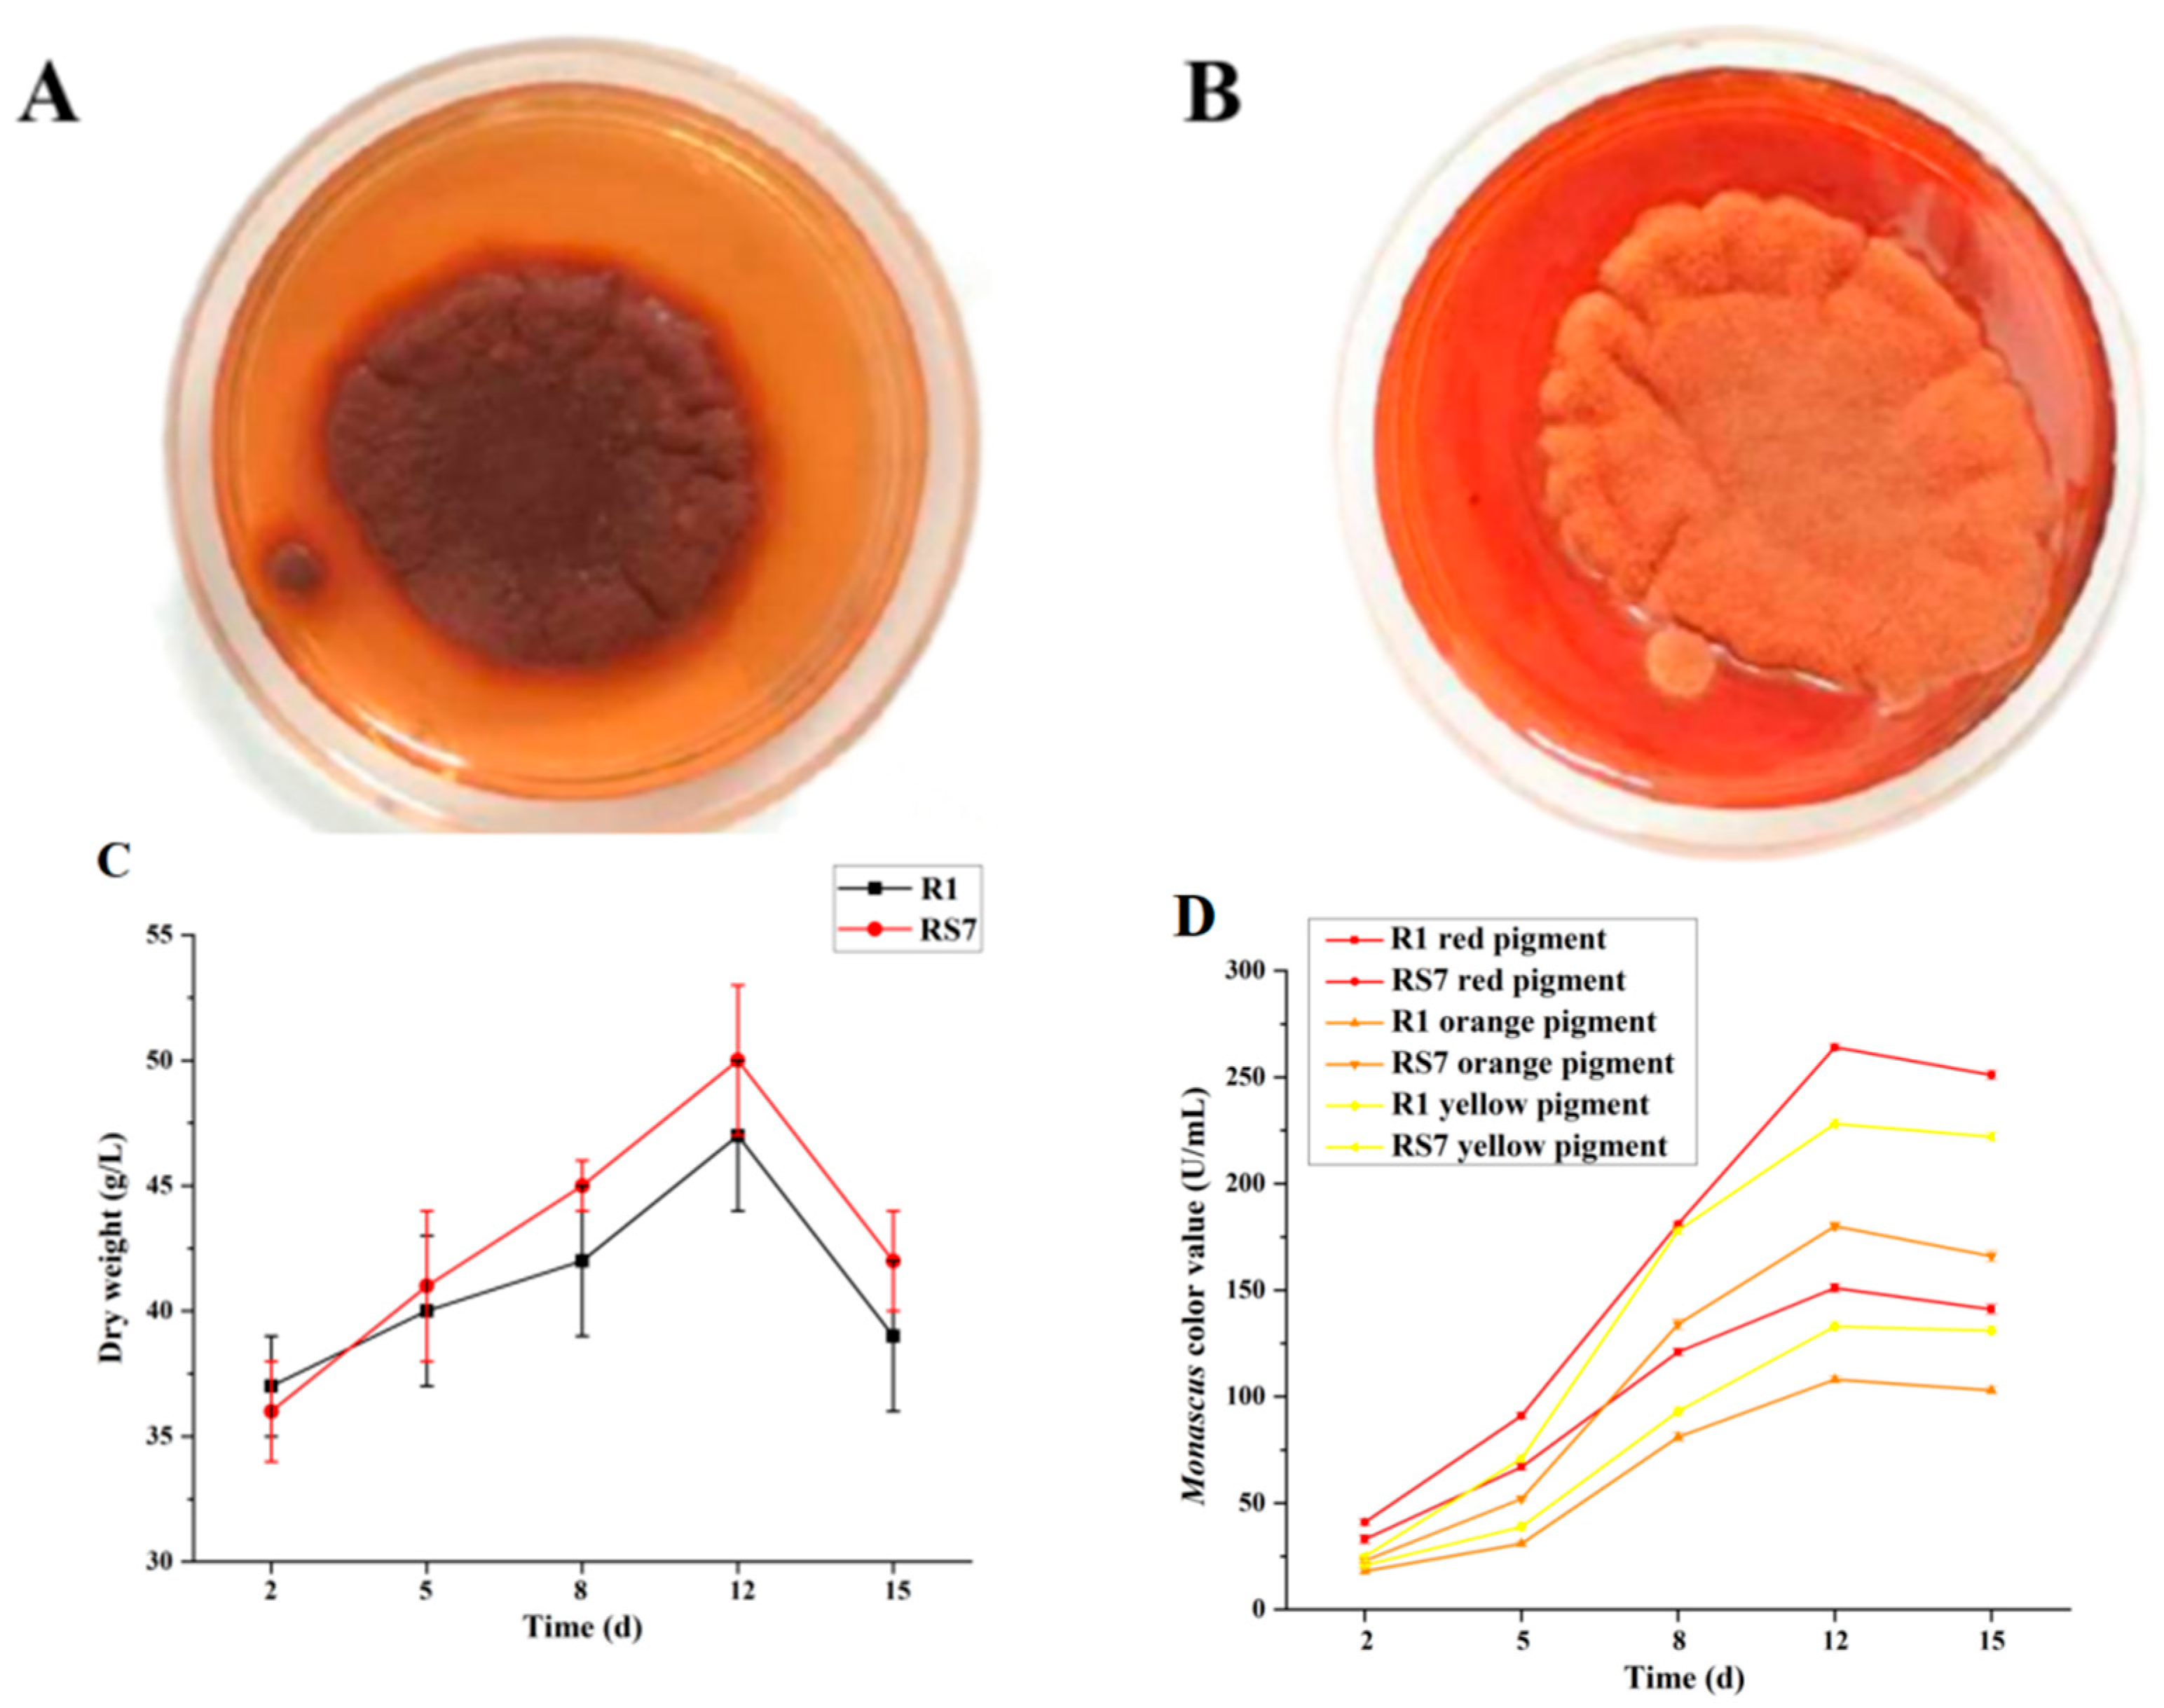
Jof 10 00553 g002 Jof 10 00553 g002

Mutation Breeding of Monascus to Produce a High Yield of Orange Pigment and Low Citrinin Content Using the ARTP Method
Abstract
1. Introduction
2. Materials and Methods
2.1. Strains and Materials
2.2. Preparation of Different Spore Concentrations
2.3. ARTP Mutagenesis and Mutagenic Lethality
2.4. Screening of Strains
2.5. Determination of Pigments Color Value and the Comparison of Colony Color
2.6. Determination of Citrinin Content
2.7. Determination of Dry Weight of Mycelium
2.8. Observation of Scanning Electron Microscope (SEM)
2.9. Optimization of Ultrasonic Extraction Conditions for Pigments
2.10. Pigment Separation of Mutant Strain
2.11. Stability of Orange Pigment of Mutant Strains
2.12. Statistical Analysis
3. Results
3.1. The Lethal Rate of Mutant Strain and Screening of Strain
3.2. Pigment Biosynthesis and Cell Growth
3.3. Single-Factor Extraction and Response Surface Optimization for Ultrasonic Extraction
3.4. MPS Separation
3.5. Stability of MPs
4. Discussion
5. Conclusions
Author Contributions
Funding
Institutional Review Board Statement
Informed Consent Statement
Data Availability Statement
Conflicts of Interest
References
- Suraiya, S.; Siddique, M.P.; Lee, J.-M.; Kim, E.-Y.; Kim, J.-M.; Kong, I.-S. Enhancement and characterization of natural pigments produced by Monascus spp. using Saccharina japonica as fermentation substrate. J. Appl. Phycol. 2018, 30, 729–742. [Google Scholar] [CrossRef]
- General, T.; Kim, H.-J.; Prasad, B.; Ngo, H.T.A.; Vadakedath, N.; Cho, M.-G. Fungal utilization of a known and safe macroalga for pigment production using solid-state fermentation. J. Appl. Phycol. 2014, 26, 1547–1555. [Google Scholar] [CrossRef]
- Zhang, X.W.; Zhao, Y.X.; Yan, W.Y.; Wang, P.H.; Li, J.; Lu, Y.J. Light stability and mechanism of Monascus pigment under different lights. LWT 2024, 191, 115666. [Google Scholar] [CrossRef]
- He, L.M.; Liu, C.; Chen, S.; Zhang, J.L.; Gao, M.X.; Li, L. Precursor-directed production of water-soluble red Monascus pigments with high thermal stability via azaphilic addition reaction-based semi-synthesis. Food Chem. X 2023, 20, 100940. [Google Scholar] [CrossRef] [PubMed]
- Hasan, S.M.; Talukder, T.A.; Mizanur, H.; Suvro, T.; Rovina, K.; Nurul, H.; Wahidu, Z. Nitrites in Cured Meats, Health Risk Issues, Alternatives to Nitrites: A Review. Foods 2022, 11, 3355. [Google Scholar] [CrossRef] [PubMed]
- Wu, H.C.; Cheng, M.J.; Wu, M.D.; Chen, J.J.; Chen, Y.L.; Chang, H.S.; Chen, K.P. Secondary metabolites from the fermented rice of the fungus Monascus purpureus and their bioactivities. Nat. Prod. Res. 2019, 33, 3541–3550. [Google Scholar] [CrossRef] [PubMed]
- Li, X.M.; Shen, X.H.; Duan, Z.W.; Guo, S.R. Advances on the Pharmacological Effects of Red Yeast Rice. Chin. J. Nat. Med. 2011, 9, 161–166. [Google Scholar]
- Dajung, J.; Deokyeong, C.; Kyunghwa, N.; Soo, S.C. Biological evaluation of novel derivatives of the orange pigments from Monascus sp. as inhibitors of melanogenesis. Biotechnol. Lett. 2014, 36, 1605–1613. [Google Scholar]
- Choe, D.; Lee, J.; Woo, S.; Shin, C.S. Evaluation of the amine derivatives of Monascus pigment with anti-obesity activities. Food Chem. 2012, 134, 315–323. [Google Scholar] [CrossRef]
- Vendruscolo, F.; Tosin, I.; Giachini, A.J.; Schmidell, W.; Ninow, J.L. Antimicrobial Activity of Monascus Pigments Produced in Submerged Fermentation. J. Food. Process. Preserv. 2014, 38, 1860–1865. [Google Scholar] [CrossRef]
- Erkaya, S.; Arslan, N.P.; Orak, T.; Esim, N.; Taskin, M. Evaluation of tyrosol and farnesol as inducer in pigment production by Monascus purpureus ATCC16365. J. Basic Microbiol. 2020, 60, 669–678. [Google Scholar] [CrossRef]
- Li, Y.L.; Zhao, Y.H.; Zhang, H.Z.; Ding, Z.; Han, J. The Application of Natural Carotenoids in Multiple Fields and Their Encapsulation Technology: A Review. Molecules 2024, 29, 967. [Google Scholar] [CrossRef] [PubMed]
- Huang, Z.B.; Zang, S.Y.; Xu, Y.; Li, L.S.; Li, Y.P. Development of an HPLC–UV Detection Method for the Simultaneous Determination of Two Monascus Orange Pigments in Red Yeast Rice. Food Anal. Methods 2016, 9, 148–155. [Google Scholar] [CrossRef]
- Hajjaj, H.; Klaébé, A.; Loret, M.O.; Goma, G.; Blanc, P.J.; François, J. Biosynthetic Pathway of Citrinin in the Filamentous Fungus Monascus ruber as Revealed by 13C Nuclear Magnetic Resonance. Appl. Environ. Microbiol. 1999, 65, 311–314. [Google Scholar] [CrossRef] [PubMed]
- Magdalena, T.; Iwona, A.; Robert, K. Dietary Supplements Based on Red Yeast Rice—A Source of Citrinin? Toxins 2021, 13, 497. [Google Scholar] [CrossRef] [PubMed]
- Li, Z.; Liu, Y.; Li, Y.; Lin, F.; Wu, L. Screening and identification of Monascus strains with high-yield monacolin K and undetectable citrinin by integration of HPLC analysis and pksCT and ctnA genes amplification. J. Appl. Microbiol. 2020, 129, 1410–1418. [Google Scholar] [CrossRef] [PubMed]
- Wang, Y.L.; Gao, H.; Xie, G.H.; Li, X.J.; Huang, Z.B. Effects of some flavonoids on the mycotoxin citrinin reduction by Monascus aurantiacus Li AS3.4384 during liquid-state fermentation. AMB Express 2020, 10, 26. [Google Scholar] [CrossRef] [PubMed]
- Zhu, L.S.; Long, P.C.; Man, H.; Wang, L.L.; Shao, Y.C.; Cheng, S.Y.; Dong, X.X.; He, Y. Insight into selenium biofortification and the selenite metabolic mechanism of Monascus ruber M7. Food Chem. 2024, 455, 139740. [Google Scholar] [CrossRef] [PubMed]
- Zhang, C.; Zhang, H.; Zhu, Q.Q.; Hao, S.; Chai, S.Y.; Sun, B.G.; Wang, C.T. Overexpression of global regulator LaeA increases secondary metabolite production in Monascus purpureus. Appl. Microbiol. Biotechnol. 2020, 104, 3049–3060. [Google Scholar] [CrossRef]
- Dikshit, R.; Tallapragada, P. Development and screening of mutants from Monascus sanguineus for secondary metabolites production. Beni-Suef Univ. J. Basic Appl. Sci. 2018, 7, 235–240. [Google Scholar] [CrossRef]
- Torres, N.R.; Banas, K.; Bialk, P.; Bloh, K.M.; Kmiec, E.B. Insertional Mutagenesis by CRISPR/Cas9 Ribonucleoprotein Gene Editing in Cells Targeted for Point Mutation Repair Directed by Short Single-Stranded DNA Oligonucleotides. PLoS ONE 2017, 12, e0169350. [Google Scholar]
- Magneschi, L.; Catalanotti, C.; Subramanian, V.; Dubini, A.; Yang, W.; Mus, F.; Posewitz, M.C.; Seibert, M.; Perata, P.; Grossman, A.R. A mutant in the ADH1 gene of Chlamydomonas reinhardtii elicits metabolic restructuring during anaerobiosis. Plant Physiol. 2012, 158, 1293–1305. [Google Scholar] [CrossRef] [PubMed]
- Wang, N.; Long, T.; Yao, W.; Xiong, L.; Zhang, Q.; Wu, C. Mutant Resources for the Functional Analysis of the Rice Genome. Mol. Plant 2013, 6, 596–604. [Google Scholar] [CrossRef] [PubMed]
- Krishnan, A.; Guiderdoni, E.; An, G.; Hsing, Y.I.C.; Han, C.D.; Lee, M.C.; Yu, S.M.; Upadhyaya, N.; Ramachandran, S.; Zhang, Q.; et al. Mutant resources in rice for functional genomics of the grasses. Plant Physiol. 2009, 149, 165–170. [Google Scholar] [CrossRef] [PubMed]
- Zhang, Q.; Miao, R.; Feng, R.; Yan, J.; Wang, T.; Gan, Y.; Zhao, J.; Lin, J.; Gan, B. Application of Atmospheric and Room-Temperature Plasma (ARTP) to Microbial Breeding. Curr. Issues Mol. Biol. 2023, 45, 6466–6484. [Google Scholar] [CrossRef] [PubMed]
- Li, J.; Guo, S.; Hua, Q.; Hu, F. Improved AP-3 production through combined ARTP mutagenesis, fermentation optimization, and subsequent genome shuffling. Biotechnol. Lett. 2021, 43, 1143–1154. [Google Scholar] [CrossRef] [PubMed]
- Xu, X.; Niu, C.T.; Liu, C.F.; Wang, J.J.; Zheng, F.Y.; Li, Q. A Novel Approach to Develop Lager Yeast with Higher NADH Availability to Improve the Flavor Stability of Industrial Beer. Foods 2021, 10, 3057. [Google Scholar] [CrossRef] [PubMed]
- Chen, G.; Tang, R.; Tian, X.F.; Qin, P.; Wu, Z.Q. Change of Monascus pigment metabolism and secretion in different extractive fermentation process. Bioproc. Biosyst. Eng. 2017, 40, 857–866. [Google Scholar] [CrossRef] [PubMed]
- Hao, H.; Qin, X.; Belwal, T.; Li, L.; Aalim, H.; Wu, Q.; Duan, Z.H.; Zhang, X.; Luo, Z. Ultrasonic impact on viscosity and extraction efficiency of polyethylene glycol: A greener approach for anthocyanins recovery from purple sweet potato. Food Chem. 2019, 283, 59–67. [Google Scholar]
- Zheng, S.J.; Zhang, G.M.; Wang, H.J.; Long, Z.Q.; Ting, W.; Li, Q.G. Progress in ultrasound-assisted extraction of the value-added products from microorganisms. World J. Microbiol. Biotechnol. 2021, 37, 71. [Google Scholar] [CrossRef] [PubMed]
- Li, M.G.; Zhou, C.S.; Wang, B.; Zeng, S.Y.; Mu, R.Y.; Li, G.H.; Li, B.Z.; Lv, W.Q. Research progress and application of ultrasonic- and microwave-assisted food processing technology. Compr. Rev. Food Sci. Food Saf. 2023, 22, 3707–3731. [Google Scholar] [CrossRef] [PubMed]
- Shen, Z.D.; Kong, X.M.; Yu, Q.; Yang, Z.X. Research Progress of Thin Layer Chromatography and Surface Enhanced Raman Scattering Spectroscopy. Spectrosc. Spect. Anal. 2021, 41, 388–394. [Google Scholar]
- Vivar, M.; Pichel, N.; Fuentes, M. Solar disinfection of natural river water with low microbiological content (10–103 CFU/100mL) and evaluation of the thermal contribution to water purification. Sol. Energy 2017, 141, 1–10. [Google Scholar] [CrossRef]
- Zhang, C.; Liang, J.; Yang, L.; Chai, S.Y.; Zhang, C.X.; Sun, B.G.; Wang, C.T. Glutamic acid promotes monacolin K production and monacolin K biosynthetic gene cluster expression in Monascus. AMB Express 2017, 7, 22. [Google Scholar] [CrossRef] [PubMed]
- Ghani, Z.A.; Yusoff, M.S.; Zaman, N.Q.; Zamri, M.F.M.A.; Andas, J. Optimization of preparation conditions for activated carbon from banana pseudo-stem using response surface methodology on removal of color and COD from landfill leachate. Waste Manag. 2017, 62, 177–187. [Google Scholar] [CrossRef]
- Szabó, A.; Takács, K.; Kalinák, C.; Erdélyi, B. Thin-layer chromatographic method for separation of wheatgrass pigments on sucrose impregnated silica gel plates. JPC—J. Planar Chromatogr. 2012, 25, 361–362. [Google Scholar] [CrossRef]
- Magdalena, K.; Małgorzata, S.Ż.; Grażyna, K. Carotenoid determination in recent marine sediments—Practical problems during sample preparation and HPLC analysis. Chem. Lett. 2017, 6, 91–104. [Google Scholar]
- Zheng, H.; Yao, D.H. Study on the optimization of solid-state fermentation conditions of Monascus pigment and its stability. China Condiment 2016, 41, 26–31. [Google Scholar]
- Ye, L.T.; Ye, R.F.; Hu, F.X.; Wang, G.Z. Combination of atmospheric and room temperature plasma (ARTP) mutagenesis, genome shuffling and dimethyl sulfoxide (DMSO) feeding to improve FK506 production in Streptomyces tsukubaensis. Biotechnol. Lett. 2021, 43, 1809–1820. [Google Scholar] [CrossRef]
- Chen, G.; Yang, S.Z.; Wang, C.T.; Shi, K.; Zhao, X.H.; Wu, Z.Q. Investigation of the mycelial morphology of Monascus and the expression of pigment biosynthetic genes in high-salt-stress fermentation. Appl. Microbiol. Biotechnol. 2020, 104, 2469–2479. [Google Scholar] [CrossRef]
- Loret, M.O.; Morel, S. Isolation and structural characterization of two new metabolites from Monascus. J. Agric. Food Chem. 2010, 58, 1800–1803. [Google Scholar] [CrossRef] [PubMed]
- Liu, H.Q.; Huang, Z.F.; Yang, S.Z.; Tian, X.F.; Wu, Z.Q. Inducing red pigment and inhibiting citrinin production by adding lanthanum(III) ion in Monascus purpureus fermentation. Appl. Microbiol. Biotechnol. 2021, 105, 1905–1912. [Google Scholar] [CrossRef] [PubMed]
- Yang, X.L.; Xiang, L.B.; Dong, Y.; Cao, Y.P.; Wang, C.T. Effect of nonionic surfactant Brij 35 on morphology, cloud point, and pigment stability in Monascus extractive fermentation. J. Sci. Food Agric. 2020, 100, 4521–4530. [Google Scholar] [CrossRef] [PubMed]
- Matej, P.; Kristyna, S.; Barbora, B.; Petra, P. Effect of initial pH, different nitrogen sources, and cultivation time on the production of yellow or orange Monascus purpureus pigments and the mycotoxin citrinin. Food Sci. Nutr. 2019, 7, 3494–3500. [Google Scholar]
- Chen, S.; Liu, T.; Wang, S.; Wang, Y.Y.; Pan, W.Y.; Li, L. The stability of yellow and orange Monascus pigments. Sci. Technol. Food Ind. 2021, 42, 19–24. [Google Scholar]
- Wei, M.; Zhu, J.J.; Gao, H.S.; Yao, H.H.; Zhai, C.P.; Nie, Y. An efficient method for improving the stability of Monascus pigments using ionic gelation. J. Sci. Food Agric. 2023, 103, 6190–6197. [Google Scholar] [CrossRef]
- Yang, Y.J.; Xia, Y.J.; Song, X.; Mu, Z.Y.; Qiu, H.Z.; Tao, L.R.; Ai, L.Z. The Potential of Flos sophorae immaturus as a Pigment-Stabilizer to Improve the Monascus Pigments Preservation, Flavor Profiles, and Sensory Characteristic of Hong Qu Huangjiu. Front. Microbiol. 2021, 12, 678903. [Google Scholar] [CrossRef]
- Yin, X.Q.; Li, Y.Y.; Zhou, Z.W.; Rao, S.Q.; Du, Z.C.; Chen, J.; Liu, S. Enhanced Production of Transglutaminase in Streptomyces mobaraensis through Random Mutagenesis and Site-Directed Genetic Modification. J. Agric. Food Chem. 2021, 69, 3144–3153. [Google Scholar] [CrossRef]
- van Gessel, A.F.H.; Carbone, E.A.D.; Bruggeman, P.J.; van der Mullen, J.J.A.M. Laser scattering on an atmospheric pressure plasma jet: Disentangling Rayleigh, Raman and Thomson scattering. Plasma Sources Sci. Technol. 2012, 21, 015003, (9pp). [Google Scholar] [CrossRef]
- Gong, P.F.; Shi, R.Y.; Liu, Y.T.; Luo, Q.Q.; Wang, C.T.; Chen, W. Recent advances in monascus pigments produced by Monascus purpureus: Biosynthesis, fermentation, function, and application. LWT 2023, 185, 115162. [Google Scholar] [CrossRef]
- Kale, S.P.; Cary, J.W.; Baker, C.; Walker, D.; Bhatnagar, D.; Bennett, J.W. Genetic analysis of morphological variants of Aspergillus parasiticus deficient in secondary metabolite production. Mycol. Res. 2003, 107 Pt 7, 831–840. [Google Scholar] [CrossRef] [PubMed][Green Version]

Disclaimer/Publisher’s Note: The statements, opinions and data contained in all publications are solely those of the individual author(s) and contributor(s) and not of MDPI and/or the editor(s). MDPI and/or the editor(s) disclaim responsibility for any injury to people or property resulting from any ideas, methods, instructions or products referred to in the content. |
© 2024 by the authors. Licensee MDPI, Basel, Switzerland. This article is an open access article distributed under the terms and conditions of the Creative Commons Attribution (CC BY) license (https://creativecommons.org/licenses/by/4.0/).
Share and Cite
Zhang, C.; Sun, Q.; Yang, L.; Ablimit, A.; Dong, H.; Wang, H.; Wang, C.; Wang, C. Mutation Breeding of Monascus to Produce a High Yield of Orange Pigment and Low Citrinin Content Using the ARTP Method. J. Fungi 2024, 10, 553. https://doi.org/10.3390/jof10080553
Zhang C, Sun Q, Yang L, Ablimit A, Dong H, Wang H, Wang C, Wang C. Mutation Breeding of Monascus to Produce a High Yield of Orange Pigment and Low Citrinin Content Using the ARTP Method. Journal of Fungi. 2024; 10(8):553. https://doi.org/10.3390/jof10080553
Chicago/Turabian StyleZhang, Chan, Qing Sun, Le Yang, Arzugul Ablimit, Huijun Dong, Haijiao Wang, Congcong Wang, and Chengtao Wang. 2024. "Mutation Breeding of Monascus to Produce a High Yield of Orange Pigment and Low Citrinin Content Using the ARTP Method" Journal of Fungi 10, no. 8: 553. https://doi.org/10.3390/jof10080553
APA StyleZhang, C., Sun, Q., Yang, L., Ablimit, A., Dong, H., Wang, H., Wang, C., & Wang, C. (2024). Mutation Breeding of Monascus to Produce a High Yield of Orange Pigment and Low Citrinin Content Using the ARTP Method. Journal of Fungi, 10(8), 553. https://doi.org/10.3390/jof10080553

